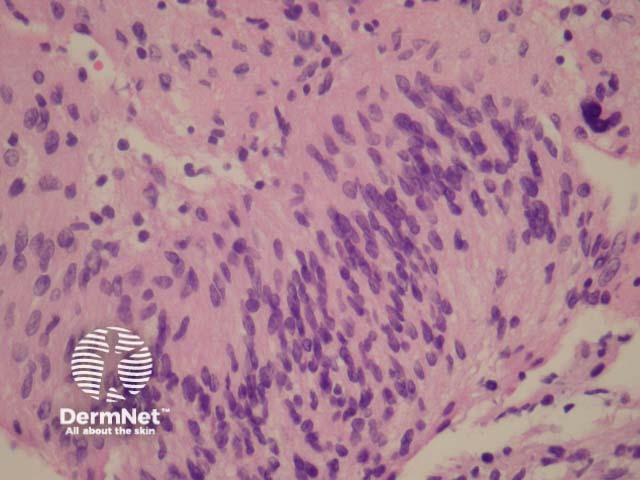
Figure 3
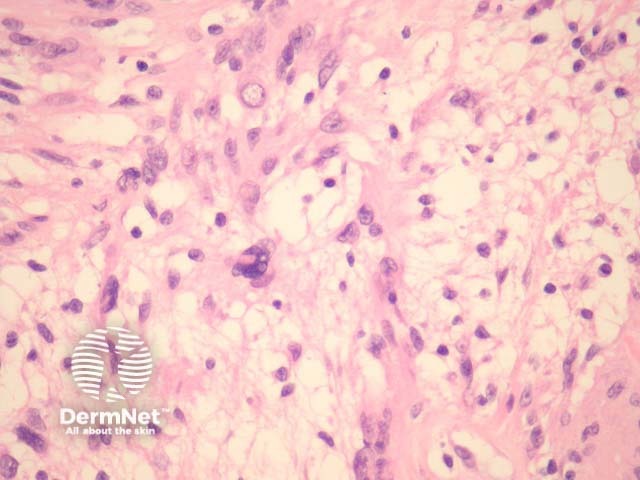
Figure 4

Main menu
Common skin conditions
NEWS
Join DermNet PRO
Read more
Quick links
Lesions (benign) Diagnosis and testing
Author: Assoc Prof Patrick Emanuel, Dermatopathologist, Auckland, New Zealand, 2013.
Schwannoma is also known as an “neurilemmoma”, “neurolemmoma”, and “Schwann cell tumour”. It is a benign peripheral nerve sheath tumour composed of Schwann cells. Schwann cells normally produce the insulating myelin sheath covering peripheral nerves.
In schwannoma, sections show an encapsulated well-circumscribed lesion beneath the uninterrupted epidermis. The tumour is composed of different areas composed of different cellular densities. More cellular areas (Antoni A, figure 1) are composed of a haphazard arrangement of bland cells with spindled and oval nuclei. Loose, less cellular areas (Antoni B, figure 2) are composed of a loose oedematous and mucinous stroma with fibrillar collagen. The vessels are prominent and often surrounded by a dense sclerosis.
Characteristic Verocay bodies may be seen (figure 3). These consist of parallel columns of elongated nuclei on either side of a homogeneous acellular material.
An associated peripheral nerve can usually be seen.
Occasionally, “ancient change” or cellular atypia believed to be a reactive phenomenon may be seen (figure 4).

Figure 1

Figure 2
Figure 3
Figure 4
Schwannomas are strongly positive with S100.
Neurofibroma – Lacks the Antoni A and B pattern of schwannoma and is not encapulated. Plexiform neurofibroma may resemble schwannoma. Neurofibromas typically have nerves coursing through the mass which can be demonstrated with immunohistochemical staining with neurofilament.
Perineurioma – These are EMA positive and S100 negative.
Dermatofibromasarcoma protuberans – These are positive with CD34, lack S100 positivity and lacks the Antoni A and B pattern of schwannoma. Additionally, they are not encapulated.